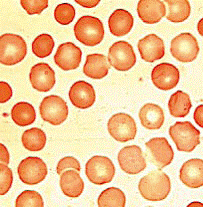

![]() | Alimentatie | Asistenta sociala | Frumusete | Medicina | Medicina veterinara | Retete |
Boala are evolutie cronica cu agravari si ameliorari.
Forma severa de sferocitoza ereditara se intalneste la 5-10% din cazuri. Acesti bolnavi sunt dependenti de transfuzii.
Forma usoara de sferocitoza ereditara se intalneste in 20-30% din cazuri. Pe parcursul evolutiei acestor bolnavi pot sa apara crize severe de hemoliza.
Fig.18. Sferocitoza ereditara
Tratament
Se administreaza permanent acid folic si coleretice: anghirol, colebil.
Splenectomia se practica numai la pacientii simptomatici. Datorita riscului crescut de infectii mortale, mai ales cu pneumococ, nu este indicata sub varsta de 5 ani.
La toti pacientii la care se practica splenectomia ar trebui sa se administreze un vaccin antipneumococic polivalent.
Sfatul genetic are rol important in profilaxia bolii deoarece defectul bolii este genetic (Hoffman, 1998).
Copyright © 2025 - Toate drepturile rezervate